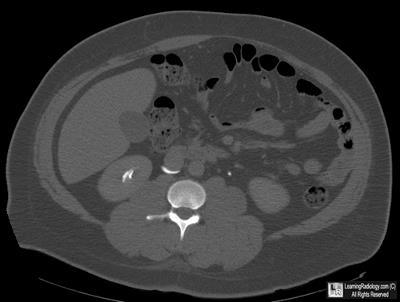

What is the most likely diagnosis?
- 37 year old male with hematuria

Coronal Reformatted CT Urogram
- Paget disease
- Bladder rupture
- Retrocaval ureter
- Retroperitoneal fibrosis
- Avascular necrosis
Additional Images-Axial CT image of abdomen

Additional Images
Axial CT image of abdomen

Answer:
3. Retrocaval ureter
More (Click Discussion Tab)
RetroCaval Ureter
General Considerations
- Also known as “circumcaval ureter”
- Abnormality in embryogenesis of IVC
- Results from abnormal persistence of right subcardinal vein positioned ventral to ureter in the definitive IVC
- Developing right ureter courses behind and medial to the IVC
- Incidence
- 0.07%
- Male to female ratio of 3:1